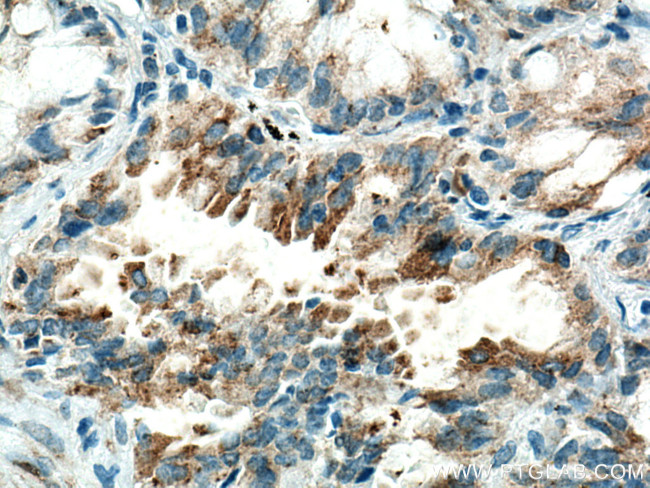
HK3 Antibody in Immunohistochemistry (Paraffin) (IHC (P))

Search
Proteintech
HK3 Monoclonal Antibody (3H3C7)
{{$productOrderCtrl.translations['antibody.pdp.commerceCard.promotion.promotions']}}
{{$productOrderCtrl.translations['antibody.pdp.commerceCard.promotion.viewpromo']}}
{{$productOrderCtrl.translations['antibody.pdp.commerceCard.promotion.promocode']}}: {{promo.promoCode}} {{promo.promoTitle}} {{promo.promoDescription}}. {{$productOrderCtrl.translations['antibody.pdp.commerceCard.promotion.learnmore']}}
产品信息
67803-1-IG
种属反应
宿主/亚型
分类
类型
克隆号
抗原
偶联物
形式
浓度
规格
纯化类型
保存液
内含物
保存条件
运输条件
产品详细信息
Aliquoting is unnecessary for -20°C storage.
靶标信息
Hexokinases phosphorylate glucose to produce glucose 6 phosphate, thus committing glucose to the glycolytic pathway. In vertebrates there are four major glucose phosphorylating isoenzymes, designated hexokinase I, II, III and IV (glucokinase). Similar to hexokinases I and II, the allosteric enzyme hexokinase III is inhibited by its product glucose 6 phosphate. The catalytic activity of hexokinase III is associated with the C terminus while regulatory function is associated with the N terminus.
仅用于科研。不用于诊断过程。未经明确授权不得转售。
篇参考文献 (0)
生物信息学
蛋白别名: ATP:D-hexose 6-phosphotransferase; hexokinase 3 (white cell); hexokinase iii; Hexokinase type III; Hexokinase-3; Hexokinase-C; Hexokinase3; HK III; kallikrein-related peptidase 3
基因别名: HK III; HK-III; HK3; HKIII; HXK3; RNU73859
UniProt ID: (Human) P52790, (Rat) P27926, (Mouse) Q3TRM8
Entrez Gene ID: (Pig) 100522855, (Human) 3101, (Rat) 25060, (Mouse) 212032